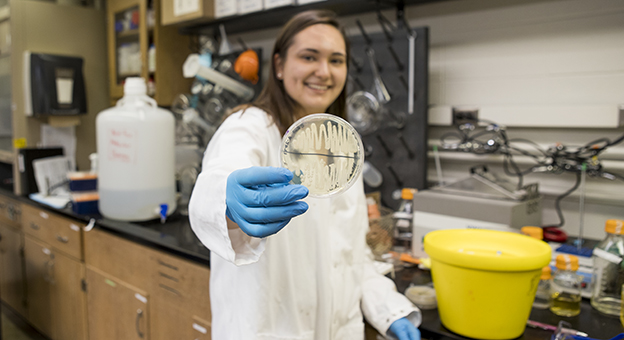

March 31, 2017
Senior Honors College biology major Ellen Wagner becomes third Ball State student to receive a National Science Foundation Graduate Research Fellowship. The prestigious award will provide her with a stipend for her graduate work at the University of Wisconsin-Madison.
March 31, 2017

The Board of Trustees approved a master of social work and a bachelor of architecture, subject to approval by the Indiana Commission for Higher Education. Trustees also named the honorary degree recipient for Spring Commencement.
March 27, 2017

“Shrek the Musical,” the story of a reclusive green ogre and his adventures in a land full of fairy tale characters, opens at Ball State University at 7:30 p.m. March 31 and April 1-2 and 4-8, with a 2:30 p.m. matinee on April 2, 8 and 9. Tickets are available at the University Theatre box office and online.
March 15, 2017
Renovations and refurbishment breathe new energy into the home of Ball State’s president as the university prepares for its 100th anniversary.
March 9, 2017
Responding to a recent act of intolerance, interim president Terry King addresses the campus community.
March 2, 2017
In his new position, William Betts will oversee the Health Center, the Counseling Center, the Testing Center, the Office of Victim Services and the Office of Health Alcohol and Drug Education. Betts came to Ball State from the University of Colorado School of Medicine.